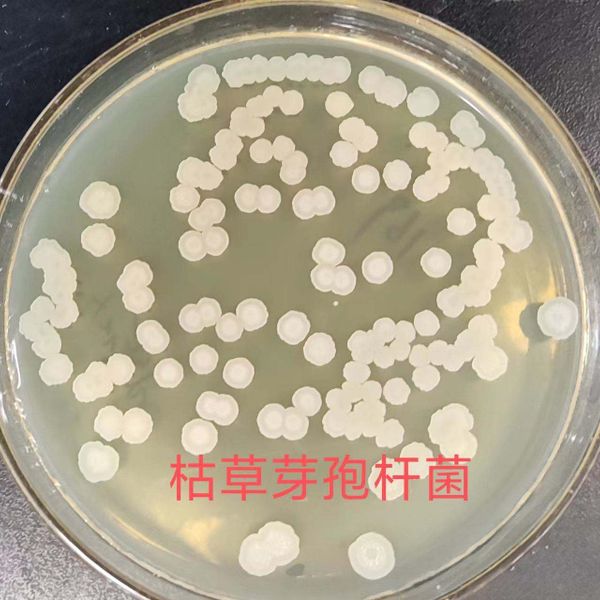

Best Probiotics Suppliers
Shanghai Unibio Lab Co., Ltd.
🇨🇳 China
202151-100 peopleManufacturer/Trading Company/Service CompanyShipments
64
Key customer
ADVANCED VITAL ENZYMES
Key market
🇳🇦 Namibia
Review
4.8

High Quality Bulk HelpGut-UNE NK Enzyme Digestive Enzyme Probiotics Capsules for Gut Health$0.1

High-Potency Probiotics Powder of Lactobacillus Reuteri Factory Supply White Appearance in Bulk Good Price$10

Factory Supply Lactobacillus Reuteri HR7 High Potency Probiotics Powder Raw Material in Bulk at Good Price$10

Factory Supply Lactobacillus Gasseri HLG13 High Potency Probiotics Powder Raw Material in Bulk at Good Price$10

High-Potency Probiotics Powder Bifidobacterium Bifidum 100B CFU/g Factory Supply in Bulk White Appearance at Good Price$10

Bulk Gut Health 100,000u/g Acid Lactase Enzyme White Powder for Lactose Intolerance Hydrolyzing Lactose in Dairy Products$5

factory Supply Clinical Studied Lactobacillus Rhamnosus GG(ATCC53103) High Potency Probiotics Powder Raw Material$300

High Strength Probiotics Containing Traditional Herbs Such As Dandelion Roots and Milk Thistle Detoxification and Skincare$5

Bifidobacterium Longum CCFM760 Probiotics$10

Factory Supply Lactobacillus Plantarum CCFM8661 High Potency Probiotics Powder Raw Material at Good Price$300

Patent Probiotic Strain Supports Oral Health, Helps Maintain Oral Microbiota Balance, Freshens Breath, Adult Chewable Tablets$5

Food Grade Probiotics Powder Enterococcus Faecium HE7 High Quality Raw Material for Supplement$10
Jinan Tiantianxiang Co., Ltd.
🇨🇳 China
199851-100 peopleManufacturer/Trading CompanyShipments
146
Key customer
MT INTERCOM
Key market
🇪🇸 Spain
Description
Jinan Tiantianxiang Co., Ltd. (TTX), established in 1998 and headquartered in Jinan, China, is a specialized manufacturer and trading company dedicated to the research, development, and production of functional feed additives. The company operates a dedicated production base and maintains a strong focus on innovation through collaborations with prestigious institutions such as Shandong University and the Shandong Province Agriculture Science Academy. Their R&D team includes professional flavorists, animal nutritionists, and microbiologists, contributing to over 10 scientific research projects and multiple patents.
The company's extensive product portfolio serves the swine, poultry, aquatic, and ruminant industries. Key offerings include feed flavors and sweeteners, oregano oil premix, mycotoxin binders, garlic allicin, feed acidifiers, and a comprehensive range of enzymes such as glucose oxidase and complex enzyme blends. Additionally, they provide biological bactericides and probiotics, including Bacillus subtilis and Bacillus licheniformis, designed to support animal health and environmental protection.
As a contract manufacturer (OEM/ODM), Jinan Tiantianxiang maintains rigorous quality standards, holding certifications such as ISO 9001, ISO 22000, HACCP, FAMI-QS, and FDA registration. With a workforce of approximately 51 to 100 employees, the company has established a global trade presence, exporting to more than twenty countries and regions across Europe, South America, Southeast Asia, the Middle East, and Africa.
Palazzo Rosa di Rosa Carlo
🇮🇹 Italy
2019Fewer than 5 peopleManufacturer/Trading CompanyKey customer
FAIRE
Key market
🇺🇸 United States
Description
Palazzo Rosa di Rosa Carlo is an Italian manufacturer and trading company established in 2019, specializing in high-functionality, organic skincare and cosmetic products. Based in Barbania, the company operates with a strong focus on research and development, combining traditional family recipes with modern processing technologies. As an ethical and sustainable brand, Palazzo Rosa emphasizes 'Made in Italy' quality, utilizing safe, natural raw materials and eco-friendly glass packaging.
The company's extensive product portfolio is built around the therapeutic properties of Organic Damask Rose Water. Their offerings are organized into several specialized lines, including anti-aging serums, probiotic skincare, and a comprehensive range of self-tanning treatments such as sprays, foams, and bio-serums. Key products include the Triple Skin Face Protection 24—designed to shield against UV rays, pollution, and blue light—as well as hyaluronic acid serums, body scrubs, and micellar waters.
Palazzo Rosa serves a demanding international clientele, including department stores, perfumeries, spas, and beauty centers. They offer OEM services and customizable options for professional partners. The company is committed to green principles, ensuring their biocertifiable collections are vegan, cruelty-free, and free from silicones and parabens. With a global strategy that includes partnerships with international luxury distributors, Palazzo Rosa positions itself as a premier ambassador of Italian luxury lifestyle and sustainable beauty.

Probiotika - Bulk in 20 Kg Barrel$37.09

Wholesale Price Bulk Supply Milk + Tonic$47.52

Cleanser - Bulk in 20 Kg Barrel$7.32

Collagen Serum - Bulk in 20 Kg Barrel$38.02

Eye Contour - Bulk in 20 Kg Barrel$40.45

Antiage Serum - Bulk in 20 Kg Barrel$39.64

Micellar Water - Bulk in 20 Kg Barrel$7.88

Body Scrub - Bulk in 20 Kg Barrel$21.56

Regenerating Face Maskk - Bulk in 20 Kg Barrel$25.03

Dry After Bath Oil - Bulk in 20 Kg Barrel$28.19

Triple Face Protection 24 - Bulk in 20 Kg Barrel$19.36

Luxury Moisturizing Face Cream & Soothing After Bath Cream with Anti-Age Probiotic Complex Organic & Natural Handmade in Italy$18.54
Shandong Yibao Biologics Co., Ltd.
🇨🇳 China
200251-100 peopleManufacturer/Trading CompanyShipments
3
Key customer
GOGAR FARMS
Key market
South America
Review
4.8

Hot Sale Nutritional Supplements Compound Probiotics Feed For Laying Hens$11

Factory-Priced Probiotics Powder 100 Billion Bacillus Subtilis Fish Growth Booster Reduces Ammonia Nitrogen Nitrite$3.5

Wholesale Aquamentia Probiotic 100 Billion Bacillus Subtilis Regulates Intestinal Health$3.5

Customizable Freeze-Dried Lactococcus Lactis Probiotics Supply$277

High Quality Enterococcus Faecium Women's Probiotic Supplement$277

Optimal Animal Breeding Biological Deodorant High Concentration Probiotics at Best Price$5

China Factory Supply Probiotics-Immunity Enhancer & Growth Promoter for Sturgeon Enterococcus Faecalis White Powder Appearance$2

Bacillus Biological Chemical Products Probiotics 60 Billion for Deodorization Fermentation Bed Bacteria$2.8

Super Quality Liquid Probiotic Feed Grade Competitive Price Compound Probiotics for Fish Dog Pig Cattle Prolong Laying Period$1.5

Best Price High Concentration Probiotics Biological Deodorant for Optimal Chicken Farm Health$5
Customizable Improve Survival Rate100 Billion Bacillus Subtilis Probiotics for Cats$3.5

High Quality Bacillus Megatherium Biological Fertilizer Improves Soil Fertility Root Growth Powder Release Controlled Plants$3
Runxin Biotechnology Co., Ltd.
🇨🇳 China
2012501-1000 peopleManufacturer/Trading CompanyKey market
North America
Review
4.9
Description
Runxin Biotechnology Co., Ltd. is a high-end healthcare industry group and professional manufacturer based in Qufu, China. Established in 2012, the company operates a 30,000 square meter facility with over 2,000 square meters of GMP-standard clean production workshops. With a workforce of 501 to 1,000 employees, the company specializes in the R&D and production of sodium hyaluronate, hyaluronic acid dermal fillers, and a comprehensive range of dietary supplements. Their manufacturing capabilities include multiple production lines for soft capsules, hard capsules, tablets, granules, powders, oral liquids, and gummies. Runxin Biotechnology is a prominent contract manufacturer (OEM/ODM) providing customized solutions for global clients in the pharmaceutical and personal care industries. Their product portfolio features specialized ingredients such as chondroitin sulfate, collagen, and coenzyme Q10, alongside finished products like multivitamins, whey protein powders, and electrolyte mixes. The company maintains rigorous quality standards, holding certifications including ISO 9001, ISO 13485, ISO 22000, FSSC 22000, GMP, HACCP, and HALAL. Runxin Biotechnology serves both domestic and international markets, with a strong export presence in North America and Africa, supported by advanced extraction lines for injection-grade materials.

Private Logo Buttock Booty Hip Enlargement Big Butt Enhancement BBL Butt Enhancement Capsules$2.2

OEM Enlargement Herbal Pills Firming Abundant Pills Breast Enhancement Supplement$2.3

Premium Inositol CoQ10 Female Fertility Capsules Vitamins Minerals Supplements Support for Women$2.5

Enhance Energy Endurance Gummies Horny Goat Weed Gummies for Men$2.3

Focus Herb Your Logo Sea Cucumber Peptide Supplement 500mg Sea Cucumber Peptide Powder$2.3

Oem Private Label Magnesium Glycinate 1mg Kids Sleep Melatonin Chewing Gum Melatonin Gummies$2.3

OEM Pueraria Mirifica Capsules Breast Enhancement Pills$2.3

OEM Private Label Sleep Nutrition Chamomile L-theanine Ashwagandha Melatonin Gummies$2.3

1000mg Bioavailable Formula Hyaluronic Acid With MSM Capsules$2.3

OEM Sports Nutrition Supplement Lemon Lime Electrolyte Salt Chews Electrolyte Tablets$2.8

Melatonin Oil for Sleep Liquid Melatonin Drops Natural Herbal Hypnotic Capsule Melatonin Spray$2.3

OEM Breast Enhancement Pueraria Mirifica Pills Estrogen Supplement$2.3
Qingdao Huineng Biotech Co., Ltd.
🇨🇳 China
201311-50 peopleManufacturer/Trading CompanyShipments
15
Key customer
ABC FRUITS
Key market
North America
Review
4.1

Postbiotic Mix Powder 10 Billion CFU/g Inactivated Probiotics Bulk Supply for Gut Health$88

Bulk Organic Food Grade Erythritol Powder/Granules Natural Zero-Carb Sweetener Drum for Coffee Desserts Dietary Supplements$1.3

Postbiotics Drink Prune Probiotics Ready to Drink for Gut Health$49

High Potency Streptococcus Salivarius Probiotics Powder Raw Material for Supplements and Health Products$88

Food Grade Bifidobacterium Infantis Powder High Purity Probiotic Vitamin C Astaxanthin Stable Content Packaged Drum Minimum$60

Postbiotics Powder Inactivated Probiotics for Women's Health Lactobacillus Reuteri$88

Lactic Ferment Lactobacillus Acidophilus Freeze-Dried Probiotics Lactobacillus Acidophilus$88

CHITI Natural Spirulina Powder Organic Pure Spirulina Powder$4.5

Bifidobacterium Breve Postbiotic$30

Lactobacillus Acidophilus$25
Veluca
🇺🇸 United States
201911-50 peopleManufacturer/Trading Company/Service Company/Wholesaler/DistributorShipments
1
Key customer
AMAZON
Key market
🇺🇸 United States
Description
Veluca is a premier B2B supply chain marketplace and contract manufacturer headquartered in Austin, Texas. Founded in 2019, the company specializes in the production and distribution of high-quality nutraceuticals and skincare products. Veluca offers one of the industry's largest selections of stock formulations, featuring over 1,000 items including gummy vitamins, capsules, softgels, tablets, and liquid supplements. Their extensive product catalog covers diverse categories such as Keto BHB, turmeric blends, marine collagen, probiotics, sea moss, and various anti-aging face serums and body butters.
As a comprehensive service provider, Veluca supports retailers, wholesalers, and Amazon sellers through private label manufacturing, custom formulations, and ODM services. The company operates a manufacturing facility and provides a suite of value-added services, including R&D, graphic design, label and packaging printing, warehousing, and fulfillment. They are particularly noted for their drop-shipping and blind-shipping capabilities, which allow partners to expand their product selection while minimizing inventory risks.
Veluca maintains rigorous quality standards, with products manufactured in facilities that are FDA registered and GMP certified. Depending on the specific product line, they also hold certifications such as NSF, Halal, Kosher, and Organic. With a focus on short lead times and competitive pricing, the company serves a global market, providing both retail-ready bottled products and bulk gummies or softgels to other manufacturers worldwide.
Xi'an Changsheng Jiuyuan Biotech Co., Ltd.
🇨🇳 China
202211-50 peopleTrading CompanyShipments
164
Key customer
CARVAGU
Key market
🇺🇸 United States
Review
1

Food Grade Lactobacillus Bulgaricus Probiotics in Chewable Capsules Tablets Spheres Bulk Powder Packaged in Drum$600

Best Price 99% Food Grade Isomalt/ Maltitol Candy Sugar Powder Factory Supplier$2.1

Food Grade Ashwagandha Extract Root Powder Wild-Cultivated Herbal Supplement in Drum Packaging Competitive Price$13

Best Price 100% Pure Natural Eucommia Oil Therapeutic Grade Herbal Extract Powder Form Food Grade Available Bottle Drum Can$30

100% Natural Pure Basil Oil Herbal Extract for Face Body Varying Options Bottle Drum Glass Container Vacuum Packed Mason Jar$18

Food Grade Isononyl Isononanoate Cosmetic Raw Materials Powder in Drum Packaging CAS 42131-25-9$20

Factory Direct Food Grade L-arginine Hcl Supplement Powder 99.0% Pure Wild Cultivated Available in Bottle Drum Can Packaging$18

High Quality 40% Isoflavones Soy Isoflavone P.E. Bean Soybean Herbal Extract Powder Form in Bottle Drum or Can Packaging$16

Cosmetic Grade Olivem 1000 Food Grade Herbal Extract Cream Packaged in Drum$30

100% Natural Allium Extract 10:1 Pure Garlic Oil Powder Herb Extract in Bottle Drum Glass Container or Vacuum Packed$15

Food Grade Allantion Powder Cosmetic Whitening Ingredients in Drum Packaging$25

Selenomethionine DL-Selenomethionine Wild Cultivation Method Powder CAS 1464-42-2$20
Healthife LLC
🇨🇳 China
202211-50 peopleTrading CompanyKey market
North America
Review
4.7
Description
Healthife LLC is a professional supplier and custom manufacturer based in Xi'an, China, specializing in the health and wellness industry. Established in 2022, the company provides an extensive range of high-quality ingredients and finished products, including plant extracts, mushroom powders, organic herb powders, and beef organ supplements. Their diverse portfolio features specialized items such as Liposomal Vitamin C, Shilajit, Tongkat Ali, and various functional food additives like vitamins, amino acids, and enzymes.
Operating as a trading company with robust custom manufacturing capabilities, Healthife LLC offers comprehensive OEM and ODM services for tablets, capsules, gummies, and blend powders. The company maintains a strong commitment to quality and safety, holding a wide array of international certifications including HACCP, GMP, FSSC 22000, ISO 22000, HALAL, Kosher, and EU Organic certification.
With a workforce of 11 to 50 employees, the company focuses on international trade, serving a global client base that includes retailers, wholesalers, and brand businesses, particularly in the United States and Canada. Healthife LLC is recognized for its reliability in the B2B marketplace, supported by strong research and development capabilities and a proven track record of on-time delivery for both raw materials and finished nutritional solutions.

CAS 1143-70-0 Cosmetic Grade Urolithin-a Bulk New High Purity Urolithin-a 98% Urolithin a Powder$714.3

Healthife Probiotics Supplement 50 Billion CFU Daily 6 Unique Strains Probiotics Capsule for Women$2.5

Healthife CAS 137-08-6 Vitamin B5 99% D-Calcium Pantothenate Powder$42

Healthifet Private Label Pre Workout Performance Chewable Pure Creatine Monohydrate 90 Gummies$3.2

Healthife Supply Wholesale Chlorella Extract OD1200 CGF Chlorella Growth Factor Powder$50

Wholesale Brain Function Supplements Alpha Glycerylphosphorylcholine CAS 28319-77-9 Alpha GPC Tablets$4.5

USA Warehouse Pure High Quality High Purity Spermidine 0.2% 0.5% 1% Fermented Wheat Germ Extract Powder$57.2

Healthife US Warehouse Supply CAS 53-84-9 NAD+ Nicotinamide Adenine Dinucleotide 99% NAD Powder$143

Heaithife Berberine Supplements 60ml Berberine Hydrochloride Liquid Drops$2.5

USA Warehouse CAS 1143-70-0 Supplement Urolithin a Powder 3,8-Dihydroxyurolithin 98% Urolithin a$0.86

Supplements Fermented Rice Bran Extract Spermidine Powder 0.2% 0.5% 1% Spermidine$85.8

Healthife OEM Dietary Supplement Grass Fed Bovine Beef Pancreas Capsules$2.5
ORIENT BIOTECH SDN. BHD.
🇲🇾 Malaysia
199551-100 peopleManufacturer/Trading Company/Wholesaler/DistributorKey market
🇲🇾 Malaysia
Description
ORIENT BIOTECH SDN. BHD. (operating as Bonlife) is a premier Malaysian manufacturer and distributor specializing in functional foods, beverages, and health supplements. Established in 2004 and headquartered in Batu Caves, Selangor, the company operates as a subsidiary of OB Holdings Berhad. With over 30 years of in-house manufacturing expertise, the company serves a diverse clientele including reputable pharmacies, MLM organizations, and international partners through its comprehensive OEM and ODM services.

Bonguard Probiotic Supplement$2.66

Purenat Premium Goat Milk Powder All Natural Nutrient-Rich Powdered Milk for Babies Toddlers Adults Older Age Golden Nutrition$18